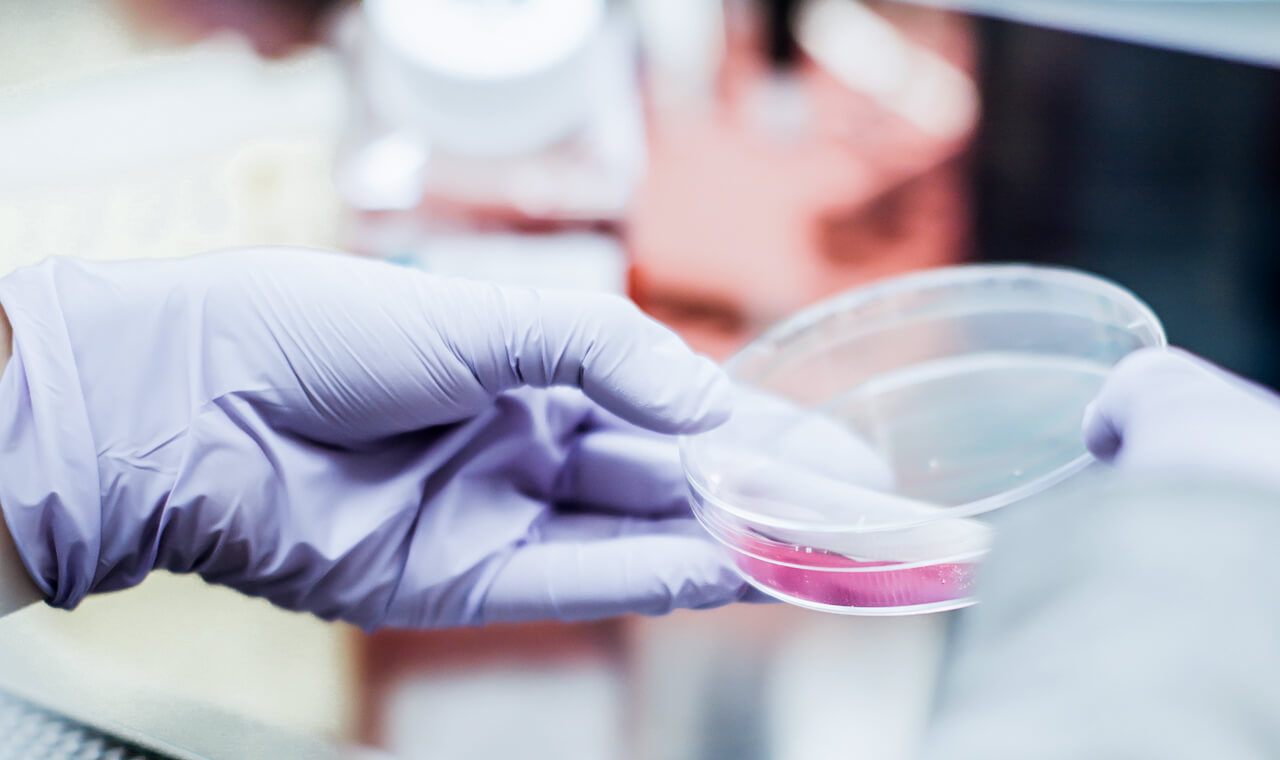
Design Rossetto

Il laboratorio
Più di 40 anni di ricerca e innovazione in campo enologico.Un team esperto di analisti, consulenti e ricercatori.
Azienda
Dal 1980 POLOLAB, fondato da Maurizio Polo, offre servizi di analisi enologiche e per il settore agroalimentare, rapidi e di alta qualità, nel rispetto degli standard internazionali, ponendo costantemente il cliente al centro della propria organizzazione.

Le nostre garanzie
Siamo in grado di garantire:
Consulenze personalizzate per la gestione di situazioni complesse.
Dalla valutazione del grado di maturazione delle uve all’imbottigliamento, non esiste un problema senza soluzione. I nostri enologi sono in grado di assistere le aziende nel pianificare e gestire ogni tipologia di attività di cantina. Lo staff, formatosi negli anni, cresce costantemente con l’ingresso di nuovi tecnici e laureati e può offrire un servizio puntuale e risolutivo. Laboratorio Polo è in grado di seguire l’intero ciclo viticolo, definendo con il cliente la strategia più adeguata ad ottenere uve e vini di ottima qualità. Nel tempo abbiamo affinato la nostra particolare sensibilità ai temi dell’ambiente, adeguando la struttura al fine di fornire servizi e assistenza per la produzione di vini biologici.Massima focalizzazione sull'innovazione scientifica grazie alla collaborazione con università e istituti di ricerca.
Logistica di qualità superiore, con invio dei risultati dopo solo 24/36 ore dalla presa del campione (entro la giornata per il Triveneto).
Costi contenuti, elevata qualità e tempi di risposta ridotti al minimo.
La struttura e il gruppo
Oggi POLOLAB sorge in un'area di 13.000 mq, accanto agli stabilimenti di Bioenologia 2.0.
Con oltre 1.000 metri quadri di laboratorio, POLOLAB dispone di strumentazioni all'avanguardia e può contare su un team di 40 persone, tra tecnici e microbiologi molecolari, che lo collocano a livello nazionale tra le eccellenze del settore. 20.000 test effettuati ogni anno, garantiscono la qualità di oltre 70 milioni di bottiglie.
Mission
POLOLAB si prefigge di fornire ad aziende e professionisti servizi di elevata qualità nell’ambito delle analisi di laboratorio, sofisticate soluzioni e protocolli di gestione dei processi produttivi per il settore enologico e agroalimentare.

Vision
POLOLAB adotta standard internazionali allo scopo di posizionarsi all'apice delle eccellenze nel panorama del settore, mediante un'offerta all'avanguardia in ambito professionale, tecnologico e organizzativo.
Compete per garantire sicurezza, efficacia, efficienza e tempestività.
Centralità del cliente. Il cliente è al centro del processo aziendale e la struttura si adatta ed evolve costantemente per rispondere alle sue esigenze in modo rapido, sicuro, efficace.
Valorizzazione dei collaboratori. Il personale di POLOLAB possiede elevate competenze professionali e tecniche, frutto della continua attività di aggiornamento e condivisione.
Eccellenza. POLOLAB persegue con tenacia il miglioramento continuo dei propri standard qualitativi e di sicurezza, nel rispetto del sistema di qualità totale e dei requisiti richiesti dalle certificazioni adottate dall'azienda. Ogni nuova problematica è una sfida da affrontare con rigore e razionalità.
Sostenibilità. Coscienza verde non è solo uno slogan; POLOLAB ha installato nei propri stabilimenti tre impianti fotovoltaici, il primo nel 2011, con una produzione complessiva di 230.000 kWh annui. Inoltre, tutto il processo aziendale è orientato alla sostenibilità, con una maniacale attenzione agli sprechi e all'impatto con l'ambiente.
